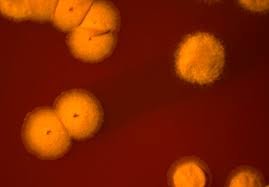

New bacterial species infected by man: Nocardia donostiensis
The new bacterium identified by researchers from the University Hospital of Donostia, the CIBERES Group and the UPV has been called Nocardia donostiensis.
The group analyzes the diseases caused by the bacteria of the genus Nocardia. These bacteria affect people who have previously suffered from respiratory diseases, neoplasms, etc. On this occasion, a new species not described in the respiratory samples of patients has been detected and characterized.
For its recognition as a new species it is necessary to carry out biochemical studies and genetic sequences, such as comparing with similar species present in international collections. In addition, it should be published in a journal on new taxonomic contributions. The process has been prolonged. But the researchers have taken advantage of their presence in 2016 and, being Donostia European Capital of Culture, they have called the new species Nocardia donostiensis.
Buletina
Bidali zure helbide elektronikoa eta jaso asteroko buletina zure sarrera-ontzian